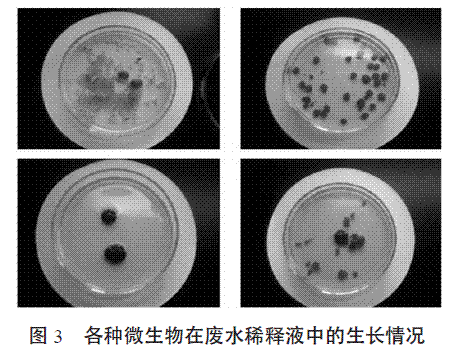

我国是聚氨酯合成革(简称PU革)及其基布的生产大国,浙江省温州、丽水等地是我国革基布及合成革的主要生产基地。丽水市水阁工业区,有多达62家的合成革、革基布及相关企业,形成了国内第二大合成革生产基地。随着丽水市经济的发展和市区人口的增加,工业废水和生活污水的排放量迅速增加,丽水市城市污水处理厂的规模已不能适应城市发展的需求。据估计,在丽水的水阁工业区生产革基布的企业有11家,革基布产量达45000万米/年,废水产生量达23000吨/天。目前,丽水水阁工业区的革基布废水治理以各企业分散处理为主。各革基布企业一般单独建有废水处理设施,但经处理后排放的革基布废水对当地环境仍造成不同程度的影响。因此,需要对现有的废水处理设施进行一系列的优化和改进。对革基布生产工艺产生的废水采用化学混凝沉淀和生物处理相结合的方法,是有效的,技术上和经济上都是可行的。本文研究了生物法处理革基布生产废水,重点探讨生产废水的高效微生物处理。
1.材料与方法
1.1废水样本
废水取自丽水经济开发区水阁工业园区同丰制革有限公司革基布生产废水的第一道出水口和最终出水口。
1.2菌种
分离自丽水学院校园不同环境土壤的3种真菌(M-Ⅰ、M-Ⅱ、M-Ⅲ)、1种细菌(X-Ⅰ)和1种放线菌(F-Ⅰ),丽水学院微生物实验室保存的菌种米曲霉、黑曲霉、大肠杆菌、枯草芽孢杆菌和普通变形杆菌,共有10个菌株。
1.3培养基
PDA固体培养基、查氏液体培养基、革基布废水培养基(根据需要配制不同稀释度和添加不同营养物质的培养基)。
1.4实验方法
1.4.1革基布生产废水微生物处理后pH和OD600值的变化
革基布在整理染色过程中,会掉落很多细小绒毛纤维,废水中悬浮物很多,因此需对废水连续进行3次过滤。
将实验室保存的米曲霉、黑曲霉、大肠杆菌、枯草杆菌和普通变形杆菌以及从土壤分离纯化出来的M-Ⅰ、M-Ⅱ、M-Ⅲ、X-Ⅰ、F-Ⅰ分别活化培养后,吸取5mL加入5倍稀释的废水中发酵培养,并于120r/min,28℃摇床振荡培养,3d为一个培养周期,每24h取样一次分别测定pH和OD600值(取平均值)。
1.4.2霉菌对革基布废水的处理
将前面保存的霉菌米曲霉、M-Ⅰ、M-Ⅱ和M-Ⅲ进行菌种活化和扩大培养,吸取5mL菌液分别接种至装有5倍稀释废水中,120r/min,28℃摇床振荡培养24h,并观察结果。
2.结果与讨论
2.1革基布生产废水微生物处理后pH值变化结果革基布生产废水微生物处理后pH值变化结果见图1。

在米曲霉、普通变形杆菌和F-Ⅰ的发酵液中,酸碱度逐渐升高;在M-Ⅰ、M-Ⅱ、M-Ⅲ的发酵液,酸碱度逐渐下降;枯草杆菌、大肠杆菌和黑曲霉的发酵液中,pH值先上升后下降;而废水稀释液中加入了X-Ⅰ,发酵液的pH值先下降后又有所上升。其中经米曲霉72h处理的废水pH值接近7.0,处理效果相对较好。
pH值的变化不大,培养菌液pH值基本保持在6.0~8.0之间变动。这说明,微生物在生长过程中具有自动调节培养环境中pH值的能力,使培养液pH值保持在一定的良好生长条件下。这一点与游映玖、曾明秀等人的研究结果不谋而合。
2.2革基布生产废水微生物处理后OD600值变化结果
革基布生产废水微生物处理后OD600值变化结果见图2。

普通变形杆菌、黑曲霉、M-Ⅱ和M-Ⅲ的发酵液中,OD600值都有所升高;米曲霉、枯草杆菌和X-Ⅰ加入废水稀释液后,使发酵液的OD600下降;大肠杆菌、普通变形杆菌的发酵液OD600,在波长为600nm的吸光度时先有上升的趋势,后又有所下降;而只有M-Ⅰ的发酵液的OD600先下降,后又会上升。
在各种微生物发酵液的OD600值随时间变化中,黑曲霉、M-Ⅰ、M-Ⅱ和M-Ⅲ有明显地上升趋势,说明这几种微生物在废水稀释液中生长繁殖较快,环境条件比较适合它的生长;故以后可以优先考虑选择它们用于革基布生产废水的生物处理。
2.3霉菌对革基布废水的处理结果
经过24h的摇床振荡发酵培养,废水发酵液中有球状菌团生成,说明了所选的各种微生物能够在废水稀释液中生长繁殖,且生长状况良好,见图3。
3.结论
实验结果表明:在试验的10种微生物中,所用霉菌菌种M-Ⅰ、M-Ⅱ、M-Ⅲ、米曲霉和黑曲霉对革基布生产废水的处理效果较好,今后有必要对霉菌处理革基布废水作进一步的研究。














